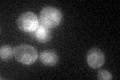
YIL030C
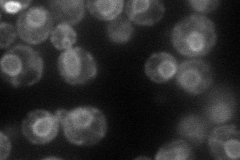
YIL030C
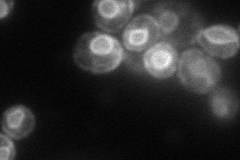
YIL030C
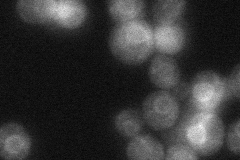
YIL030C
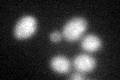
YIL030C
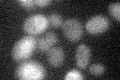
YIL030C

View description
Ubiquitin-protein ligase involved in ER-associated protein degradation; located in the ER/nuclear envelope; ssm4 mutation suppresses mRNA instability caused by an rna14 mutation
Localization:
Intensity:
Fold change:
Significance:
-
C’ GFP library in SD
ER29.74 -
N' NOP1pr-GFP in SD
ER87.7988 -
N' TEF2pr-mCherry in SD
ER82.4306 -
N' NATIVEpr-GFP in SD
ER34.4576 -
N' TEF2pr-VC and Cyto-VN in SD

below threshold25.8192 -
C’ GFP library in SD+DTT
ER28.910.97No -
C’ GFP library in SD+H2O2

ER25.890.87No -
C’ GFP library in Starvation Media

ER19.310.64Yes -
C’ GFP library on the background of Pup2-DaMP
cytosol -
C’ GFP library on the background of CCT mutant

ER30.35561.02025No
